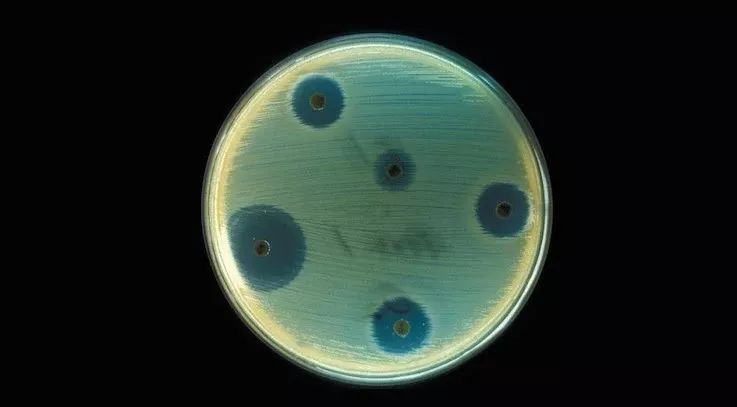

本文转载自“Dizzy纪话”,已获授权。


有一段时间,超级细菌这个关键词疯狂出现在各路媒体,以至于我一度非常反感它。直到最近我才重新拾回了对这种人类公敌的兴趣。
原因是我看了BBC地平线的《抗击超级细菌》,其中有这样一个片段。
研究者设计了一个实验来探究超级细菌的诞生过程,方法很简单,就是将一个大型培养皿分割成数个相邻的区域,在这些区域分别添加含有不同浓度抗生素的培养基。

不同区域的培养基是没有分隔的,细菌只要扛得住抗生素就能不断扩张。
实验开始,大肠杆菌从培养皿两侧没有添加抗生素的区域开始繁殖,很快它们就占满的整个区域。
接下来大肠杆菌要面对的是足够杀死它们的普通浓度抗生素,紧接着是这个浓度10倍、100倍、1000倍。
结果很多人都能猜得到,大肠杆菌经过繁殖迭代,变异出了抵抗抗生素的性状,最终连1000倍浓度的抗生素也无济于事。

到这里都没有让我感到惊讶的地方,真正让我毛骨悚然的是大肠杆菌从零开始到占领千倍浓度区域的时间仅仅用了一个星期!
也就是说在一次抗生素治疗过程中,病菌就有可能产生抗药性。很快你可能就会发现原来吃了马上起效的特效抗生素在你第二次第三次得病时就开始变得效果不佳。
这不是因为抗生素有什么缺陷,而往往是来自于病人的错误使用。
纪录片的摄制组前往亚洲那些超级细菌最猖狂的地方寻找孕育它们的摇篮。在亚洲的一些贫穷国家,超级细菌无处不在。
原因说起来有些奇怪,是因为用不起抗生素。像印度这样贫富差距极大的国家,制药厂以非常低的成本大量制造抗生素,也以非常低廉的售价销售。穷人去不起医院,有什么头疼脑热只会自己瞎买药,而便宜抗生素就是最多人的选择。

在印度,你只需要花2.5卢比,换算成人民币是3毛钱,就可以不用处方在药店买到一带子的抗生素。这些抗生素甚至没有正式的说明书,甚至不需要到药店购买。
这些随处可得的抗生素被胡乱使用,很多印度人认为抗生素能治百病,非细菌感染造成的疾病也会服用抗生素。
就算是感冒发烧这类疾病,很多人也仅仅是一片一片地购买抗生素,一片一片吃,一旦病情出现好转,为了省钱就不再服用。

这种错误的服用方式让细菌暴露在“准灭菌浓度”的抗生素环境下,不但不能彻底杀死病菌,反而给病菌留下了变异出抗药性的机会。
其实想想我们自己,有多少人没有遵循医嘱吃下整个疗程的“消炎药”(国内喜欢把抗生素叫做消炎药),总觉得自己的病症已经好转,同时也囿于“是药三分毒”古训,能不吃就不吃,殊不知这其实是在养蛊。

超级细菌的问题其实不是一个突然爆发的状况,早在青霉素刚刚研制出来的年代,就有人发现细菌会产生抗药性。
至于为什么那么多年问题都没有爆发,一方面是因为抗生素以前是稀缺药品,使用受到严格的控制。另一方面是因为医药公司一直在研发新的抗生素对抗细菌。
然而到21世纪,已经没有多少医药公司会愿意研究抗生素药品了。(以下制药产业的内容来自另一部纪录片《猎杀超级细菌》,感兴趣也可以自行搜索观看)抗生素是一种很特别的药物,它不像其他所有专利特效药一样拥有永久的寿命。50年前研发的药品到今天依旧有效,并且会永远有效。

而抗生素是唯一一种越用效果越差的药物,就像是一把弹药有限的机枪,子弹会越打越少,如果过度射击还会出现枪管发热,失去能力。当抗生素的研发变得越来越困难,投入越来越大,大公司都迫于商业盈利而放弃研发。
以抗生素发家的辉瑞是坚持到最后的大公司之一。到2008年,只有3家国际大型药企还在研发抗生素,其他都把精力放在了那些需要用一辈子的慢性病特效药,前段时间“印度药神”的主角药格列卫就是典型。

这种罕见绝症特效药不但销量稳定,还可以拿到政府的一些补贴,远比研发抗生素更有利可图。就连辉瑞在经历2011年的股市大跌后,也砍掉了坚持了70年的抗生素研发。

辉瑞生产的土霉素产品
人类与超级细菌之间的持久战,我们正在逐渐失去我们的兵工厂。我们还能不能打赢这场战争?还有希望。
传统的方法一般在泥土中寻找新的抗生素,到现在我们用的几乎所有抗生素都来自于土壤微生物,它的潜力几乎已经被我们榨干。
实际上细菌最好对手就是细菌本身,抗生素也是细菌之间竞争的产物。所以在那些资源最缺乏竞争最激烈的地方会有更强力的抗生素。于是科学家开始去到人迹罕至的地下洞穴中寻找希望。

洞穴中没有阳光,养分极少,想要在这里存活,细菌要么变得谨小慎微,要么变得极具攻击性杀死一切竞争对手。
2011年,在洞穴中就发现了一种细菌,它能产生38种不同的灭菌化合物。目前临床上常用的抗生素也不过40多种。洞穴将会是一个宝库,里面藏着很多武器。

除此之外,我们还有一个对付超级细菌的超级武器。也是老生常谈的噬菌体。作为一种以细菌为猎物的生物,无论细菌如果进化如何产生抗性,噬菌体必须保证它们自己也同步进化才能不饿死。
但是威力越大的武器就越是难研发,噬菌体只会猎杀一种细菌,也就意味着世界上存在着数以亿计的噬菌体种类。想要找到我们需要的那一种仍然非常困难。
即便找到了,也不能用一辈子,因为细菌在进化,噬菌体也在进化,只有不断地寻找才能百战百胜。另一个难点就是如何将噬菌体活体做成药品,但希望还是存在的。

而我个人觉得最有意思的是纪录片中提到的一种类似与“信息战”一样的方法。我们知道单个细菌是不会对我们造成伤害的,只有当它们繁殖到一定的数量,并且同步行动时才会对我们造成影响。
这也就意味着细菌之间能够交流,更重要的是这种交流是可控的。夏威夷短尾鱿鱼是伪装大师,但是当它捕食的时候难免会因为月光而留下影子,这会暴露它们的行踪,甚至被捕食者发现。


于是夏威夷短尾鱿鱼进化出了一种能力,它们的腹部能发光,照亮海底,从而消除阴影。而发光的是一种费式弧菌,它们生活在章鱼的腹部,受到章鱼的精准控制。章鱼的背部有光照感受器,环境有多亮它就控制细菌发出多亮的光。
费式弧菌能够被章鱼控制,说明我们也能找到控制它们的方法。费式弧菌有一个亲戚,叫做霍乱弧菌,它们都是通过一种蛋白质来发号施令的。现在我们不用管这些细菌有多强的抗药性,只需要抑制这种蛋白质的活性,再可怕的细菌也会溃不成军。

人与超级细菌才刚刚进入全面战争的状态,在我看来这场战争的残酷程度不亚于二战。超级细菌就像是英法绥靖政策下的纳粹德国,惨搓搓发展直到突然发起战争,人类才后知后觉地发现我们的武器早已经落伍过时。
这一部部关于超级细菌的纪录片,有朝一日也会成为二战全史一样的经典纪录。当然我们必须先打赢这场战争。

猜你喜欢
10000+:菌群分析 宝宝与猫狗 梅毒狂想曲 提DNA发Nature Cell专刊 肠道指挥大脑
文献阅读 热心肠 SemanticScholar Geenmedical
16S功能预测 PICRUSt FAPROTAX Bugbase Tax4Fun
生物科普: 肠道细菌 人体上的生命 生命大跃进 细胞暗战 人体奥秘
写在后面
为鼓励读者交流、快速解决科研困难,我们建立了“宏基因组”专业讨论群,目前己有国内外2300+ 一线科研人员加入。参与讨论,获得专业解答,欢迎分享此文至朋友圈,并扫码加主编好友带你入群,务必备注“姓名-单位-研究方向-职称/年级”。技术问题寻求帮助,首先阅读《如何优雅的提问》学习解决问题思路,仍末解决群内讨论,问题不私聊,帮助同行。

学习16S扩增子、宏基因组科研思路和分析实战,关注“宏基因组”

























 被折叠的 条评论
为什么被折叠?
被折叠的 条评论
为什么被折叠?








